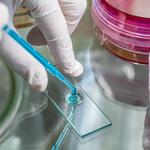

Legionella Risk Assessments Bristol
About Business
ASAP Comply Ltd offers expert Legionella Risk Assessments in Bristol, helping businesses, landlords, and property managers comply with UK health and safety regulations. Our specialists conduct thorough inspections, identifying potential risks and implementing effective Legionella control measures to prevent the spread of Legionella bacteria in water systems.
We provide comprehensive Legionella sampling services, ensuring water hygiene standards are met through accurate Legionella testing. Our assessments include detailed reports, risk management plans, and tailored solutions to keep your water systems safe and compliant. Maintaining proper water hygiene is crucial to preventing outbreaks and safeguarding public health.
In addition to Legionella Risk Assessments in Bristol, we also offer Fire Risk Assessments, providing businesses with a complete compliance package. Our commitment to high-quality service and regulatory adherence makes us a trusted partner for all water and fire safety needs.
Ensure your premises meet legal safety standards with a professional Legionella Risk Assessment in Bristol. Contact ASAP Comply Ltd today for expert advice and tailored solutions.